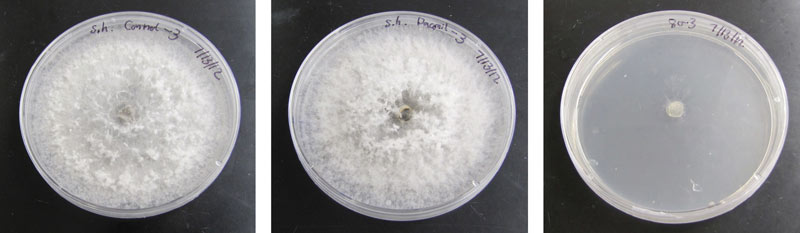

Dollar spot on a creeping bentgrass putting green at the Country Club of Columbia (Mo.). The plot area was inoculated with Sclerotinia homoeocarpa in May 2015, and fungicide application was withheld from the plot area in the rest of the growing season. The photo was taken on Aug. 27, 2015. Photos by Xiaowei Pan
Dollar spot is a common fungal disease caused by Sclerotinia homoeocarpa F.T. Benn. that affects most turf species in the United States. On golf course putting greens, dollar spot first appears as small, straw-colored patches that, left untreated, often coalesce, resulting in sunken, dead spots that adversely impact the play and aesthetics of the game of golf.
A number of cultural practices might improve dollar spot control, including frequent mowing to remove infected tissues; minimizing drought; and removing dew and guttation water in the early morning by mowing, rolling, or dragging a garden hose across the canopy (3,13).
Nitrogen deficiency has also been linked to more severe outbreaks of dollar spot (7,11,13). Although higher nitrogen rates have been thought to suppress dollar spot, nitrogen actually stimulates turf growth, which, in turn, masks the disease symptoms rather than directly affecting the pathogen (6). It is generally accepted that cultural practices alone do not provide adequate disease control, and repeated fungicide applications throughout the growing season are often necessary. Although an array of fungicides in the turf market provide superior control of dollar spot, overdependence on fungicides has led to selection of fungicide-resistant S. homoeocarpa, including documented resistance to benzimidazole and cadmium fungicides (2,3,12), as well as to dicarboximides and demethylation-inhibitor fungicides (1,4,5,8,9).
Alternatively, certain plant-based materials such as seed meal from oriental mustard (Brassica juncea (L.) Czern.), a powder-like material that remains after the oil has been extracted from the mustard seeds, may provide a non-chemical means of disease management. Mustard seed meal (MSM) contains organic nitrogen — typically around 4% to 5% based on dry weight — and secondary metabolites called “glucosinolates” (GSLs). When the meal becomes wet, GSLs are hydrolyzed to different compounds, including isothiocyanates (ITCs), which are toxic to a variety of organisms, including fungal pathogens. It is therefore possible that MSM might offer dual functions for dollar spot control, as it contains both nitrogen and GSLs.
Representative images of Sclerotinia homoeocarpa growth on petri dishes three days after being transferred from plates with two weeks of previous exposure to: a non-amended control (left), chlorothalonil (middle), and mustard seed meal equivalent to 71 pounds/acre (right). Note the growth of cotton-like mycelia filled up the entire plates in the left and middle plates, yet no regrowth is seen in the plate on the right.
Lab experiment
At the University of Missouri, a series of in vitro experiments were carried out in which colonies of S. homoeocarpa, isolated from infected creeping bentgrass (Agrostis stolonifera L.), were cultured on potato dextrose agar with or without addition of MSM (Wisconsin Spice) at different rates. In all non-amended plates, S. homoeocarpa colonies grew rapidly, filling in the entire 3.6-inch-diameter (91.44- mm-diameter) plates from less than 1⁄4-inch-diameter (6.25-mm-diameter) plugs within four days. In comparison, complete growth inhibition was observed in plates amended with MSM at rates equivalent to 89 pounds/acre (99.75 kg/hectare) or greater for two weeks. Plates containing the contact fungicide chlorothalonil (Daconil Weather Stik, Syngenta) at the label rate resulted in suppression of mycelia growth in the first 10 days, before a rapid rebound occurred over the next four days. MSM rates of 89 pounds/acre or greater were later determined to be fatal to S. homoeocarpa, as evidenced by failure of regrowth once the S. homoeocarpa mycelia were transferred to fresh plates without any amendment. Colonies that were previously exposed to chlorothalonil, however, resumed growth on fresh plates, as did non-treated colonies.
Field experiment
A two-year field experiment was also carried out on mature Penncross creeping bentgrass maintained as a golf course green in Columbia. Treatments consisted of MSM at various rates, the fungicide iprodione (26GT fungicide, Bayer) at the label rate (4 fluid ounces/1,000 square feet; 1.27 milliliters/square meter), and a non-treated control. Sequential treatment applications were initiated in mid- to late May of each year and repeated at 14-day intervals for a total of three applications per year. Under field conditions, little to no disease suppression was found at 500 pounds/acre (560.43 kg/hectare) of MSM or less, which was likely due to the escape of volatile ITCs within hours of hydrolysis. Greater rates of MSM at 1,000 or 1,500 pounds/acre (1,120.85 or 1,681.27 kg/hectare), however, showed up to 61% season-long dollar spot suppression compared with the non-treated control (Table 1, below).

Season-long disease development was expressed as area under the disease progress curve (AUDPC), which was calculated based on disease infection center counts every week through 14 weeks after initial treatment application. Three applications of iprodione in spring were not effective for season-long dollar spot control, possibly because iprodione has a limited half-life of approximately 10.6 days (10). Application of MSM at higher rates resulted in temporary chlorosis to creeping bentgrass that lasted for two weeks. Beyond six weeks after the initial treatment application, treated plots were up to 40% greener than non-treated ones, which likely resulted from the combined effects of disease suppression and the release of nitrogen from MSM.
Conclusions
Collectively, our results suggested that MSM can reduce dollar spot incidence under field conditions. As a source of organic nitrogen, MSM shows promise as part of an integrated approach for dollar spot control that could reduce reliance on conventional fungicides. It is worth noting that MSM can lead to temporary discoloration of the creeping bentgrass turf. Future research is therefore needed to develop a methodology that enhances the safety of MSM for use on intensively managed turf.
Literature cited
- Bishop P., J. Sorochan, B.H. Ownley, T.J. Samples, A.S. Windham, M.T. Windham and R.N. Trigiano. 2008. Resistance of Sclerotinia homoeocarpa to iprodione, propiconazole, and thiophanate-methyl in Tennessee and northern Mississippi. Crop Science 48:1615-1620.
- Burpee, L.L. 1997. Control of dollar spot on creeping bentgrass caused by an isolated of Sclerotinia homoeocarpa resistant to benzimidazole and demethylation-inhibitor fungicides. Plant Disease 81:1259-1263.
- Couch, H.B., and B.D. Smith. 1991. Increase in incidence and severity of target turfgrass diseases by certain fungicides. Plant Disease 75:1064-1067.
- Detweiler, A.R, J.M. Vargas Jr. and T.K. Danneberger. 1983. Resistance of Sclerotinia homoeocarpa to iprodione and benomyl. Plant Disease 67:627-630.
- Detweiler, A.R., and J.M. Vargas Jr. 1982. Resistance of Sclerotinia homoeocarpa to iprodione. Phytopathology 72:976.
- Endo, R.M. 1966. Control of dollar spot of turfgrass by nitrogen and its probable basis. Phytopathology 56:877.
- Golembiewski, R.C., and T.K. Danneberger. 1998. Dollar spot severity as influenced by trinexapac-ethyl, creeping bentgrass cultivar, and nitrogen fertility. Agronomy Journal 90:466-470.
- Golembiewski, R.C., J.M. Vargas Jr. and A.R. Detweiler. 1995. Detection of demethylation inhibitor (DMI) resistance in Sclerotinia homoeocarpa populations. Plant Disease 79:491-493.
- Jo, Y.K., A.L. Niver, J.W. Rimelspach and J.M Boehm. 2006. Fungicide sensitivity of Sclerotinia homoeocarpa from golf courses in Ohio. Plant Disease 90:807-813.
- Latin, R. 2006. Residual efficacy of fungicides for control of dollar spot on creeping bentgrass. Plant Disease 90:571-575.
- Lee J., J. Fry and N. Tisserat. 2003. Dollar spot in four bentgrass cultivars as affected by acibenzolar-s-methyl and organic fertilizers. Applied Turfgrass Science doi:10.1094/PHP-2003-0626-01-RS.
- Warren, C.G., P. Sanders and H. Cole. 1974. Sclerotinia homoeocarpa tolerance to benzimidazole configuration fungicides. Phytopathology 64:1139-1142.
- Williams, D.W., A.J. Powell Jr., P. Vincelli and C.T. Dougherty. 1996. Dollar spot on bentgrass influenced by displacement of leaf surface moisture, nitrogen, and clipping removal. Crop Science 36:1304-1309.
Xiaowei Pan is a research plant pathologist at Agriculture Development Group Inc., Eltopia, Wash.; Daniel Earlywine is a research specialist, Reid Smeda is a professor, and Xi Xiong is an associate professor in the Department of Plant Sciences, University of Missouri, Columbia, Mo.